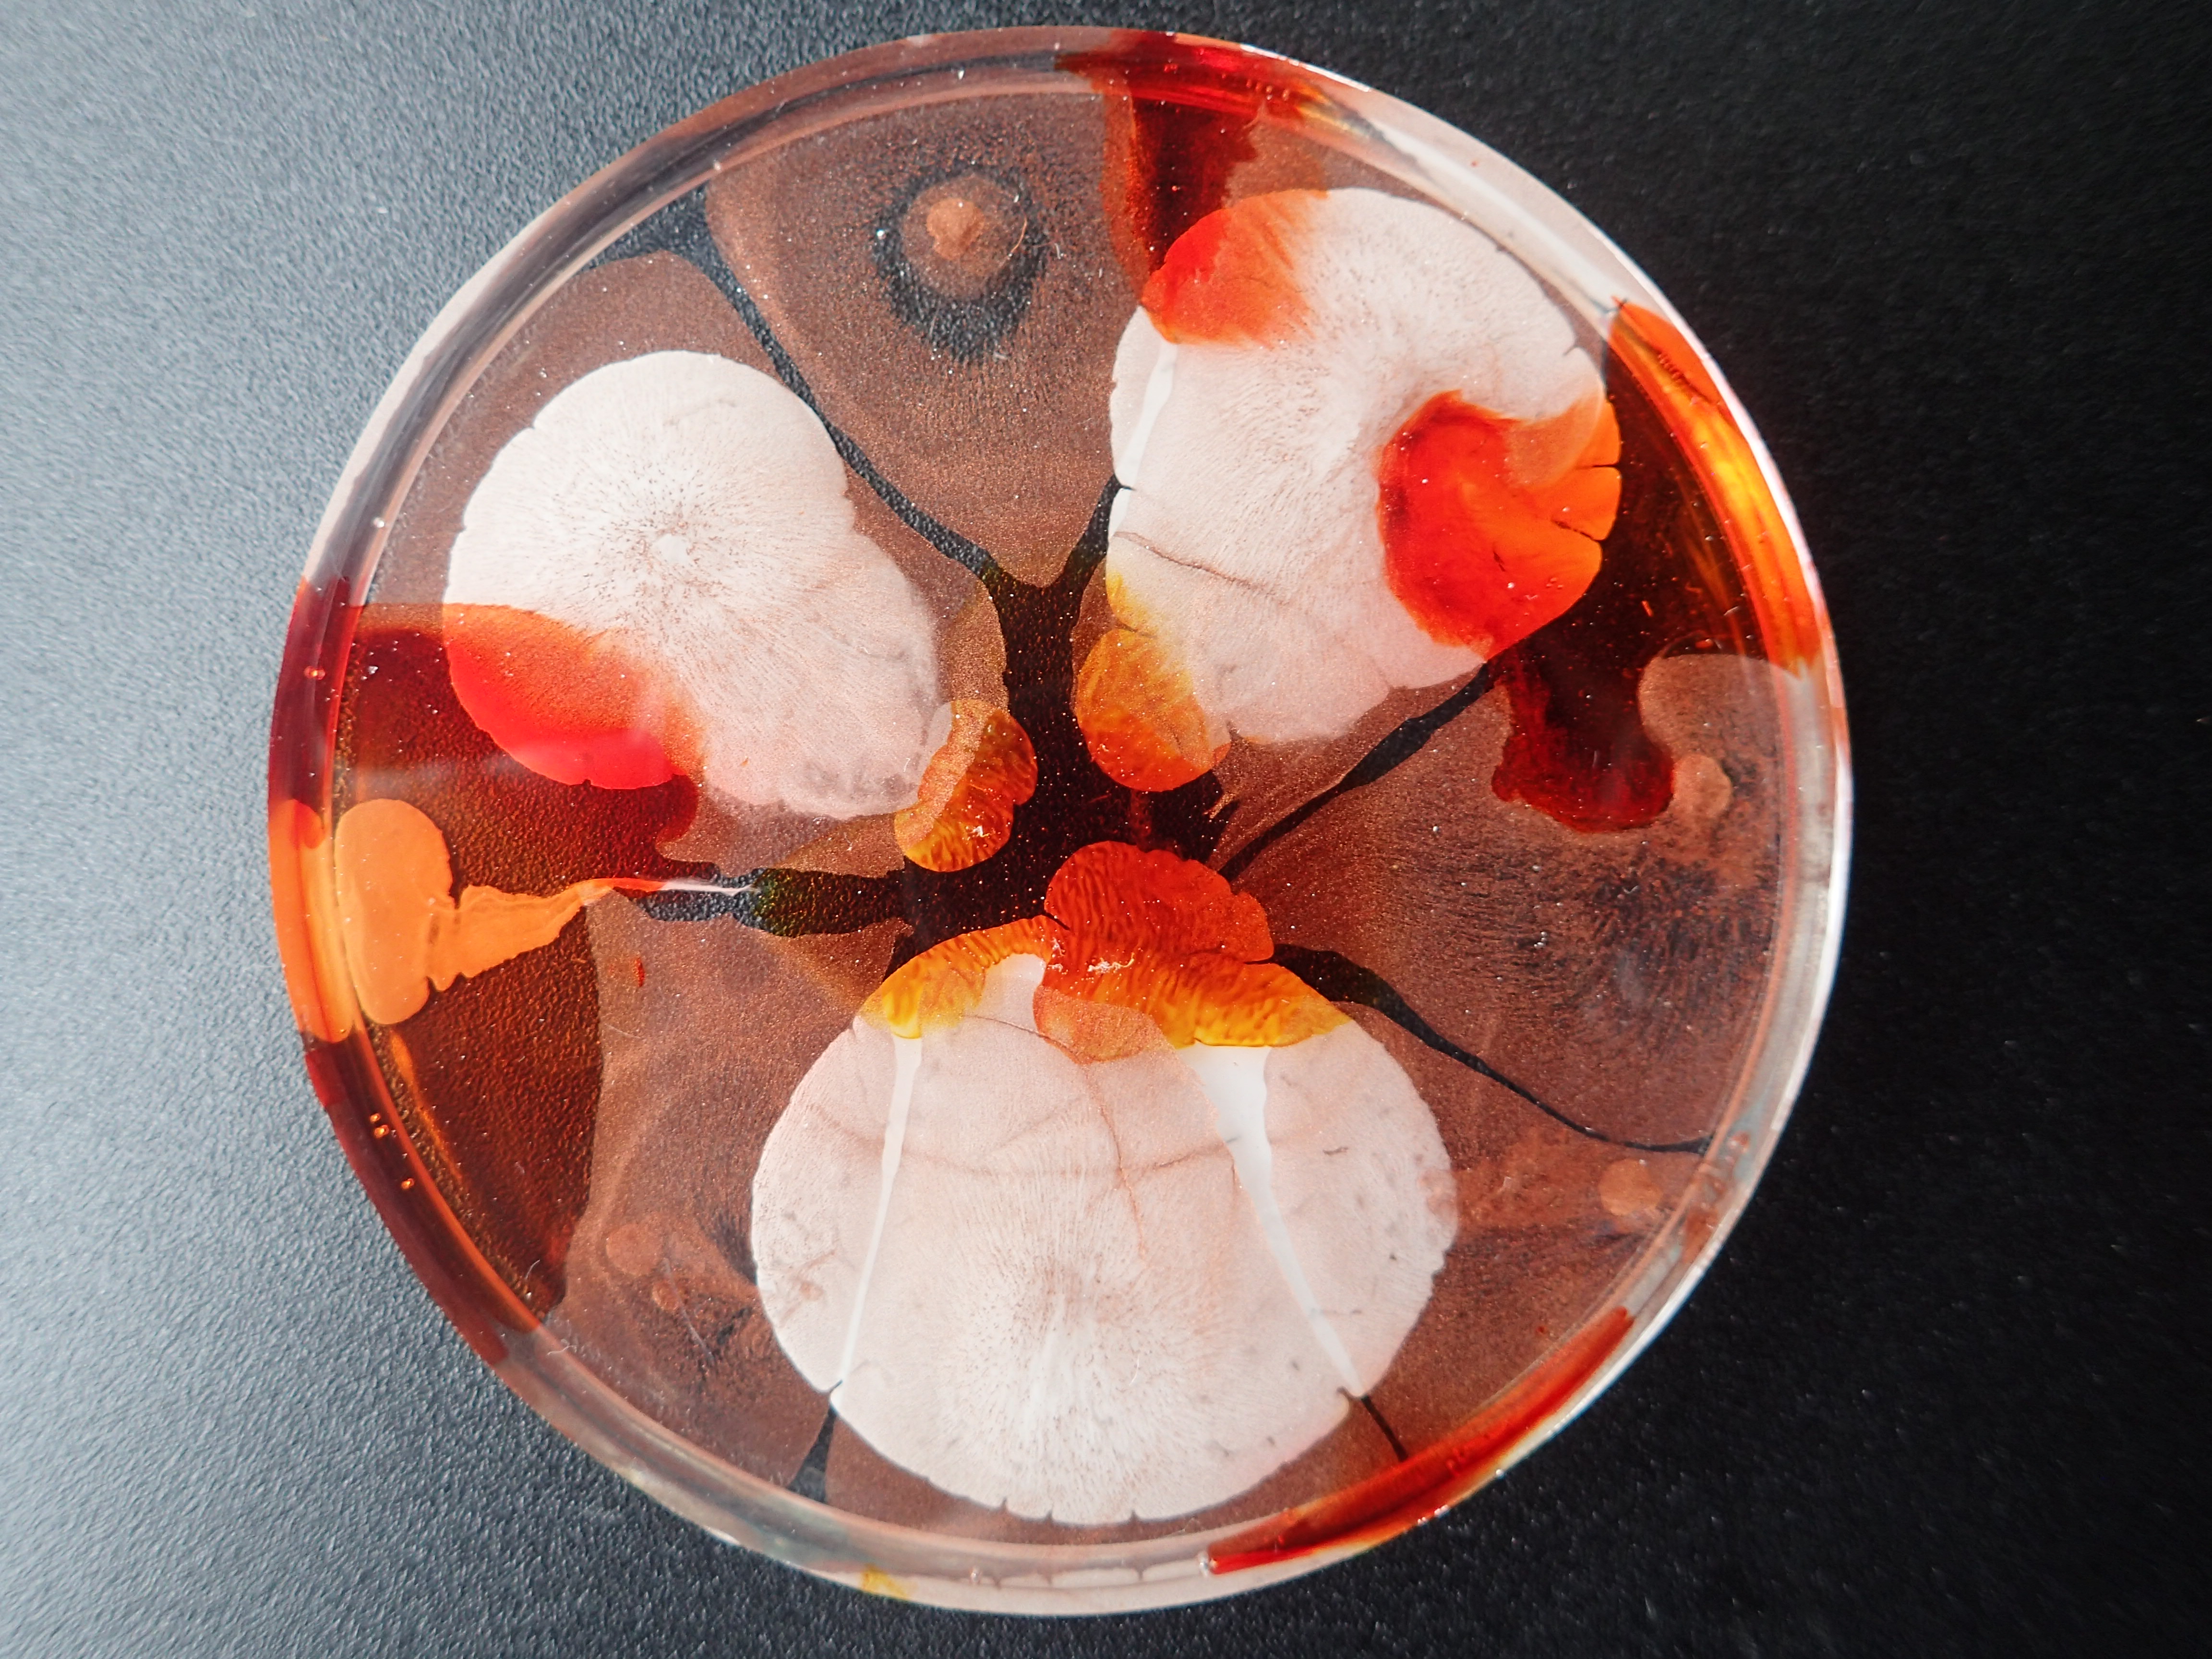

lapland impressions (2) – botanical gem. laplands fells conceal mysteries. this is no surprise, since they have been there for so many tens of millions of years just where they are today. telling me never ending stories. mixed media: inks, metallic pigments, bio-resin etc. on ceramic and wood.

lapland impressions (2) – botanical gem. mixed media: inks, metallic pigments, resin etc. on ceramic and wood.

lapland impressions (2) – botanical gem. mixed media: inks, metallic pigments, resin etc. on ceramic and wood.

detail of lapland impressions (2) – botanical gem. mixed media: inks, metallic pigments, resin etc. on ceramic and wood.

lapland impressions (2) – botanical gem. mixed media: inks, metallic pigments, resin etc. on ceramic and wood.

lapland impressions (1) – like an emerald. mixed media: inks, metallic pigments, alcohol, resin etc. on ceramics. this was an interesting experiment – to use alcohol for a painting, instead of drinking it 😉😂

my science – my cells (7): working in concert with one another…to keep outside out, allow necessities in, permit others to leave . the idea to have in the cells a mirror of the circle of live fascinates me!! to me this also looks like spheres that evolved in the foam of the surf between sea and land, as a primeval cell 🤗 mixed media, inter alia airbrush colours, acrylics, resin, embedded in plywood (40 x 40 cm).

my science – my cells (6): working in concert with one another…to keep outside out, allow necessities in, permit others to leave… mixed media, inter alia airbrush colours, acrylics, resin, embedded in plywood (40 x 40 cm).

brainstorming: extreme snow and freezing conditions – in my head. it’s interesting to be witnessing the multible birth of the snowflakes – till full-grown to a whiteout. that’s the true sound of the nature. anyways, warm thoughts keep the soul warm, even in stormy weather. yep, emotions are just valuefree feelings, only the poor thoughts try to classify them 😄

my anothermicroworld – geology of the soul (22). mixed media: acrylic paints, inks, mixatives and resin, all embedded in plywood (40 x 40 cm).

detail of my anothermicroworld – geology of the soul (22). mixed media: acrylic paints, inks, mixatives and resin, all embedded in plywood (40 x 40 cm).

detail of my anothermicroworld – geology of the soul (22). mixed media: acrylic paints, inks, mixatives and resin, all embedded in plywood (40 x 40 cm).

detail of my anothermicroworld – geology of the soul (22). mixed media: acrylic paints, inks, mixatives and resin, all embedded in plywood (40 x 40 cm).

detail of my anothermicroworld – geology of the soul (22). mixed media: acrylic paints, inks, mixatives and resin, all embedded in plywood (40 x 40 cm).

detail of my anothermicroworld – geology of the soul (22). mixed media: acrylic paints, inks, mixatives and resin, all embedded in plywood (40 x 40 cm).

detail of my anothermicroworld – geology of the soul (22). mixed media: acrylic paints, inks, mixatives and resin, all embedded in plywood (40 x 40 cm).

my anothermicroworld – geology of the soul (22). mixed media: acrylic paints, inks, mixatives and resin, all embedded in plywood (40 x 40 cm).

detail

detail

detail

detail

my anothermicroworld – geology of the soul: ice is melting (23). mixed media: acrylic paints, inks, resin on metal, all embedded in plywood (40 x 40 cm).

complex (2) – just playing: playing here with the density of colours…i am amazed how they sometimes make so good connections or are repelling in a fascinating way. mixed media with acrylics, ink, layered and tinted resin on canvas.

complex (1): playing here with the density of colours…i am amazed how they sometimes make so good connections or are repelling in a fascinating way. mixed media: acrylics, inks, tinted, layered resin on canvas.

icy veins blue: acrylics, tinted resin on canvas, 50 x 50 cm.

ruska – indian summer: acrylics, polymer binder, resin on wooden canvas, 50 x 50 cm. the very last colour gasp of the mother earth is completely insane, and i am fully addicted into it…especially in lapland. the colours of fall are even more insane, there, in lapland’s autumn…just to fall in love 😂: they glow, are bright; their fiery shades are just incredible in the fall, in the polar zone. my head is in fire, my feet in permafrost…(sold)

cyani – moments remembered. acrylic paints, inks, and resin on plywood (30 x 50 cm).

polar night – the sun is just an idea: mystical time within the polar circles, when the sun no longer rises above the horizion at all…enigmatic!! mixed media: acrylic paints, acrylate polymer emulsion resin on wooden canvas (50 x 50 cm), sold.

my cosmos. mixed media: inter alia acrylic paints, alcohol, resin on wooden canvas (50 x 50 cm), sold.

my anothermicroworld – looking for pearls: mixed media, inter alia acrylics, inks, metallic pigments, oil based pens, resin in plywood (40 x 40 cm).

my smallworld (3) mixed media: acrylic inks polymer binder and resin on wooden canvas (50 x 50 cm), sold

my smallworld (3) mixed media: acrylic inks polymer binder, resin on wooden canvas (50 x 50 cm), sold

get down to heaven – ancient jellyfish roaming the seas. mixed media: acrylics, tinted resin on wooden canvas (55 x 65 cm).

my smallworld (2). mixed media: acrylic inks polymer binder, resin on wooden canvas (50 x 50 cm), sold

my smallworld (2). mixed media: acrylic inks polymer binder, resin on wooden canvas (50 x 50 cm), sold

my smallworld (1). mixed media: acrylic inks polymer binder, resin on wooden canvas (50 x 50 cm), sold

my anothermicroworld (5) – thoughts are sometimes jewels: mixed media, inter alia inks, acrylic paints, oil bases pens, metallic pigments, layered resin – in plywood (40 x 40 cm)

my anothermicroworld (4) – sometimes blue: mixed media, inter alia inks, metallic pigments, layered resin – in plywood (40 x 40 cm)

my anothermicroworld (4) – sometimes blue: mixed media, inter alia inks, metallic pigments, layered resin – in plywood (40 x 40 cm)

irritation (2). mixed media: acrylic paints, polymer acrylic medium, airbrush inks, resin on mdf-board (50 x50 cm).

irritation. mixed media: acrylic paints, polymer acrylic medium, airbrush inks, resin on mdf-board (50 x50 cm). sold

my anothermicroworld (3) – gilded saga in black and white (10 / 1-10). mixed media: resin, acrylic paints, inks and metallic pigments, embedded in plywood. sold

my anothermicroworld (3) – gilded saga in black and white (9 / 1-10). mixed media: resin, acrylic paints, inks and metallic pigments, embedded in plywood. sold

my anothermicroworld (3) – gilded saga in black and white (8 / 1-10). mixed media: resin, acrylic paints, inks and metallic pigments, embedded in plywood. sold

my anothermicroworld (3) – gilded saga in black and white (7 / 1-10). mixed media: resin, acrylic paints, inks and metallic pigments, embedded in plywood. sold

my anothermicroworld (3) – gilded saga in black and white (6 / 1-10). mixed media: resin, acrylic paints, inks and metallic pigments, embedded in plywood. sold

my anothermicroworld (3) – gilded saga in black and white (5 / 1-10). mixed media: resin, acrylic paints, inks and metallic pigments, embedded in plywood.

my anothermicroworld (3) – gilded saga in black and white (4 / 1-10). mixed media: resin, acrylic paints, inks and metallic pigments, embedded in plywood. sold

my anothermicroworld (3) – gilded saga in black and white (3 / 1-10). mixed media: resin, acrylic paints, inks and metallic pigments, embedded in plywood. (sold)

my anothermicroworld (3) – gilded saga in black and white (2 / 1-10). mixed media: resin, acrylic paints, inks and metallic pigments, embedded in plywood.

my anothermicroworld – gilded saga in black and white (1, 1-10). mixed media: resin, acrylic paints, inks and metallic pigments, embedded in plywood. (sold)

my microworld (2). mixed media: resin, acrylic inks, alcohol inks, all embedded in plywood. (sold)
my microworld (1). mixed media: resin, acrylic inks, alcohol inks, all embedded in plywood. (sold)

my anothermicroworld – fixed hearts of gold (2): mixed media, inter alia inks, acrylic paint, metallic pigments, mixatives, layered resin – all embedded in plywood (40 x 40 cm).

growing serie: mixed media, inter alia inks, acrylic paint, metallic pigments, mixatives, layered resin – all embedded in plywood (40 x 40 cm).

my anothermicroworld – my limits (1): mixed media, inter alia acrylic paints, inks, metallic pigments – all embedded in plywood (40 x 40 cm)

I call this work „the blue hour“ in lapland.
tiny acrylic paintings embedded in resin spheres, on wooden canvas (80 cm).
my title has nothing to do with sadness, but with the magical colours of the polar night: around and above the arctic circle, polar night starts at the end of november and lasts some 52 days. sometimes from 10 o’clock in the „morning“ the magic works its wonders in blue. a few hours later the stars begin their twinkling, and night falls…at 2.00 in the afternoon 🌟 SOLD





mixed media: bio resin, inks, acrylics and neodym magnets on ferromagnetic steel plate (40x40cm).
life is like a colourful jigsaw of joyful and saddening moments: thousands of emotions and experiences. there are no wrong pieces, just ones, which patiently need to search for their own places. the princely lifetime is given to gather my picture together. and not a bit is missing. life is now!! today I may lose the sun, just to become the beauty of the starry night. it’s not too late to take a new direction, to live a new story or to build up a new dream…🖤💙🧡💛💚💜❤️








déjà vu.
mixed media: bio resin, inks, acrylics and neodym magnets on ferromagnetic steel/wooden frame (40x40x5cm). a déjà vu is a very enigmatic, crazy adventure indeed. a phenomenon that seems inaccessible, abnormal and really weird to those who have never experienced it. how does that come out? there are so many theories, but we are still a long way from really understanding the origin of the déjà vu experience. so, this sensation still retains its mystical aura…honestly, don’t you think, some mysteries are better left unsolved 🤔😉 SOLD







déjà vu.
mixed media: bio resin, inks, acrylics and neodym magnets on ferromagnetic steel/wooden frame (40x40x5cm). a déjà vu is a very enigmatic, crazy adventure indeed. a phenomenon that seems inaccessible, abnormal and really weird to those who have never experienced it. how does that come out? there are so many theories, but we are still a long way from really understanding the origin of the déjà vu experience. so, this sensation still retains its mystical aura…honestly, don’t you think, some mysteries are better left unsolved 🤔😉 customer order SOLD

lichen and moss in the arctic
acryl, inks, alkohol, mixatives and resin on wooden canvas (40×40 cm)



